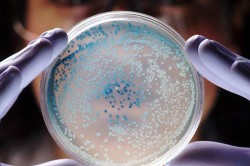
Исследование условно-патогенных микроорганизмов Исследование условно-патогенных микроорганизмов

Что собой представляют инфекции мочеполовой системы у мужчин? Если попытаться немного отойти от медицинских терминов и объяснить более просто, то это можно представить так. Есть некоторые микроорганизмы, которые попадают в эту систему человека, в данном случае — мужчины, и которые вызывают воспалительные процессы репродуктивной системы, являясь причиной болезненного отклонения ее процессов от нормального состояния или развития. В итоге такие заболевания либо проходят, а мужчина становится здоровым, либо воспалительный процесс становится хроническим, что означает периодическое возвращение симптомов болезни и ее обострения после периода выздоровления.
Неспециалисты путают между собой урогенитальные инфекции мочеполовой системы и ее заболевания, передающиеся половым путем, считая их тождественными. Дело в том, что при инфицировании происходит поражение какого-либо органа этой системы, которое может вызвать любой возбудитель. А заболевания, которые передаются половым путем, имеют специфический только для них способ распространения, и при этих заболеваниях поражаются не только органы мочеполовой системы, но и органы других систем организма. То есть инфекции и заболевания различаются между собой по разным признакам. Поэтому к инфекциям мужской мочеполовой системы относят такие заболевания, как воспаление разных органов системы: мочеиспускательный канал, мочевой пузырь, почки, предстательная железа, головка полового члена и другие.
Из-за чего возникают инфекции мочеполовой системы?
Среди урогенитальных инфекций мужского организма выделяют такие, как гонококк, стафилококки и стрептококки, микоплазма, кишечная и синегнойная палочки, колиформные бактерии и листерии. Многие слышали такие названия, как хламидия или трихомонада. Это тоже микроорганизмы, которые вызывают инфекции этой системы. Вы могли много раз слышать такое название, как бледная трепонема, но можете не знать, что это название сифилиса, который тоже относится к таким микроорганизмам. Еще из их списка нужно упомянуть уреаплазму, клебсиеллы, грибки, протей и различные вирусы, такие как герпес, папилломавирус и цитомегаловирус. Из всего этого многообразия только грибки кандида, кокки и кишечная палочка являются условно-патогенными микроорганизмами. Остальные относятся к сугубо патогенным.
Все эти инфекции вызывают разный тип воспалительной реакции, протекание которой вызвано возбудителем, что обусловило их разделение на специфические и неспецифические инфекции. Дело в том, что специфические инфекции вызывают симптомы и воспалительные процессы, которые присущи только им. В то время как неспецифические инфекции вызывают симптомы и воспаления, которые не имеют каких-то особых отличительных черт, их протекание ничем особенным не отличается по отношению к другим заболеваниям этой системы.
К первой категории, а именно к специфическим заболеваниям, относятся такие микроорганизмы, как бледная трепонема, или сифилис, гонорея, микст-инфекция, сочетающиеся два и более возбудителя и трихомониаз. Остальные организмы — кокки, хламидии, грибки рода кандида, вирусы и палочки — вызывают типичный воспалительный процесс, который не имеет каких-либо отличий. По этой причине, если стафилококки или хламидии вызывают аднексит, то эта болезнь будет классифицироваться как неспецифическая.
Врачи отмечают, что инфекции мочеполовой системы у мужчин могут возникать по различным причинам. Одной из основных является несоблюдение правил личной гигиены, что способствует размножению патогенных микроорганизмов. Кроме того, риск увеличивается при наличии хронических заболеваний, таких как диабет или заболевания предстательной железы. Врачи также указывают на важность половой активности, особенно при наличии незащищенных половых контактов, которые могут привести к передаче инфекций.
Признаки инфекций могут варьироваться, но наиболее распространенными являются болезненные ощущения при мочеиспускании, частые позывы к мочеиспусканию и выделения из уретры. В некоторых случаях мужчины могут испытывать боли в области таза или поясницы. Важно, чтобы пациенты не игнорировали эти симптомы и своевременно обращались за медицинской помощью, так как игнорирование может привести к серьезным осложнениям. Врачи подчеркивают, что ранняя диагностика и лечение инфекций мочеполовой системы играют ключевую роль в предотвращении дальнейших проблем со здоровьем.

Как можно заразить мочеполовую систему инфекциями?

Второй способ попадания заразы в организм мужчины заключается в том, что микробы могут попасть в уретру с кожного покрова. Попав в уретру, они начинают подниматься к почкам, что в дальнейшем приводит к воспалительной реакции. Этот способ заражения наблюдается у тех мужчин, которые пренебрегают элементарной гигиеной. И третий путь, который заключается в том, что микробы могут попадать в органы мочеполовой системы из крови или лимфы человека. Возникает закономерный вопрос о том, откуда в крови или лимфе эти микробы могут появиться? Туда они попадают из других органов, которые страдают от воспалительных процессов, например, кариеса, гриппа, ангины, воспаления легких, энтерита и колита. Даже если вам не жалко своих зубов (встречаются и такие пациенты), это не означает, что запущенный кариес негативно скажется только на зубах. Вполне возможно, что, прогрессируя, он вызовет не один воспалительный процесс в других органах системы организма.
Происходит это потому, что у разных микроорганизмов имеется разное сродство с внутренними органами. При этом у одних микробов наблюдается сродство не с одним, а с несколькими органами, что обеспечивает им возможность вызывать воспалительные процессы не в каком-то одном органе, а в нескольких. Причем в этих случаях воспаление может проходить как в каком-то отдельном органе, так и во всех сразу. К примеру, стрептококк группы В имеет указанное сродство с такими органами, как почки одновременно с миндалинами. Это означает, что данная инфекция может вызвать и гломерулонефрит, и ангину. То есть если мужчина болеет ангиной, то микроб может через кровь попасть в почки и вызвать воспалительный процесс, который будет диагностирован как гломерулонефрит. До сих пор врачам доподлинно неизвестна причина, из-за которой этот микроб может селиться и в миндалинах, и в почках.
Почему у мужчин процесс мочеполовых инфекций отличается от аналогичных процессов у женщин?

Дело в том, что чем длиннее уретра, тем микробам сложнее попасть в почки или мочевой пузырь. Этой инфекции нужно проделать немалый путь, подвергаясь в это время различным негативным для нее воздействиям. По этой причине мужским органам системы сложнее заразиться. А вот женщинам, которые обладают относительно коротким мочеиспускательным каналом, заболеть значительно проще. Инфекция не испытывает столь мощного воздействия и быстрее попадает на внутренние органы. Поэтому женщины чаще страдают от таких заболеваний, как цистит, сальпингит, аднексит и пиелонефрит.
Из-за этих особенностей строения системы все эти перечисленные заболевания, которым подвержены женщины, не так характерны для мужчин. Они больше склонны к простатиту, а могут страдать таким заболеванием, как уретрит или воспаление головки полового члена. Цистит чаще встречается у мужчин в случае несоблюдения элементарной гигиены или напрямую связан с занятием анальным сексом. Обладая более длинной уретрой, мужчины сильно страдают от уретрита, который у них проходит в более резкой и острой форме, нежели у представительниц слабого пола, и сопровождается сильным жжением на протяжении всего процесса мочеиспускания.
В быту эти различия сказываются следующим образом. Получившие от партнерши инфекционные заболевания мужчины сильно озлоблены на нее, считая, что партнерша могла бы и предупредить о том, что больна. Это необоснованная претензия, потому что женщина может и не догадываться, что является носителем. По статистике, представительницы слабого пола чаще, чем мужчины, являются переносчиками микробов, представляющих опасность для мочеполовой системы.
Инфекции мочеполовой системы у мужчин часто становятся предметом обсуждения, так как они могут вызывать значительный дискомфорт и серьезные последствия. Многие мужчины отмечают, что первыми признаками инфекции являются болезненное мочеиспускание, частые позывы к туалету и выделения из уретры. Эти симптомы могут быть ошибочно приняты за простую простуду или аллергическую реакцию, что приводит к запоздалому обращению к врачу.
Среди причин инфекций выделяют не только бактерии, но и вирусы, а также грибки. Неправильная гигиена, незащищенные половые акты и ослабленный иммунитет также играют важную роль в развитии заболеваний. Мужчины часто делятся опытом, что игнорирование первых симптомов может привести к хроническим формам инфекции, требующим длительного лечения. Поэтому важно быть внимательным к своему здоровью и не стесняться обращаться за медицинской помощью при первых признаках недомогания.
Признаки инфицирования мочеполовой системы
Есть у инфекции, которая представляет опасность для мочеполовой системы мужчин, общие и специфические признаки. Все самые распространенные инфекции мочеполовой системы сопровождаются рядом признаков, которые характерны для каждой из них. Так, в органах возникает дискомфорт, неприятный ощущения и определенная болезненность. Зуд является сопутствующим признаком того, что болезнь уже дает о себе знать. У мужчин из уретры происходят выделения, возникают покалывающие ощущения. Процесс мочеиспускания может проявлять расстройства, которые характеризуются его учащением или, наоборот, справить нужду бывает затруднительно. Кроме того, при данном процессе могут проявляться зуд и жжение. И, наконец, могут происходить некоторые визуальные изменения на наружных половых органах, например, покрытие пленкой, кондиломы и папилломы, различные пузырьки и налеты.
Если инфекция обладает свойством проявляться как-то особенно, с учетом некоторой специфики, то к вышеназванным признакам заболевания добавляются и другие ощущения и проявления. Например, при гонорее у мужчины сильно учащается мочеиспускание. Аналогично проявляет себя и трихомоноз. При сифилисе возникает язва, которая имеет плотные края. Помимо язвы инфекция проявляет себя увеличенными лимфоузлами. Другие инфекции дают о себе знать гнойным отделяемым уретры.
Как диагностировать мочеполовую инфекцию?

Во время опроса врач в подробностях выслушивает все то, на что жалуется пациент, задает уточняющие вопросы. Например, это может касаться длительности симптомов, как они проявляются и зависят ли от каких-то действий пациента. Переходя к осмотру, врач подмечает различные характеристики органов мочеполовой системы. Но наиболее действенный метод диагностики инфекций мочеполовой системы заключается в проведении лабораторных анализов. Пациенту необходимо сдать анализы мочи — общий и специальный, например, трехстаканная проба или проба Нечипоренко. Помимо анализов мочи у пациента берется анализ крови, проводится ее биохимия. Если есть подозрение на сифилис, гонорею или трихономиаз, то их можно установить только после того, как будет сделан мазок отделяемого уретры или прямой кишки.
Но, несмотря на всю полноту проводимой диагностики, ее может оказаться недостаточно для правильного определения инфекции. Если врач приходит к подобному выводу, то есть ему неизвестен действительный возбудитель инфекции, он углубляет диагностику, прибегая к более серьезным методам. Среди таких методов можно отметить иммуноферментный и радиоиммунный анализ. Доктор может прибегнуть к полимеразной цепной реакции, серологическим реакциям или к реакции иммунофлуоресценции, а также к бактериологическому посеву на среду и тесту-провокации.
Такие методы диагностики позволяют не только определить инфекцию, но и установить ее чувствительность к лекарственным препаратам, которым будет определенный антибиотик.
После этого назначенное лечение будет эффективным.

Как лечатся инфекции у мужчин?
Лечение инфекций мочеполовой системы у мужчин заключается в нескольких аспектах. Во-первых, назначенные медицинские препараты, тот же антибиотик, должны губительно воздействовать на микроб-возбудитель. Во-вторых, применяемые медикаменты должны стимулировать иммунную систему мужчины. В-третьих, лекарственные препараты могут и должны комбинироваться, что делает их применение более рациональным. Медикаменты могут вводиться внутривенно или внутримышечно, а также приниматься перорально.

Дело в том, что диагностированный микроб-возбудитель определит для лечения конкретный препарат этиотропного действия. На то, какие понадобятся антибиотики при воспалении, уроантисептик или сульфаниламид, влияет еще и сам процесс развивающейся патологии. Важно определить стадию заражения и площадь пораженных тканей. В ряде случаев, когда у пациента обнаруживаются микст-инфекции, доктор может прибегнуть и к хирургическому вмешательству, направленному на удаление пораженных участков тканей. Как правило, это те случаи, в которых распространение инфекции не может быть остановлено медикаментозно и она не обезвреживается. Вся сложность диагностики и лечения инфекций мочеполовой системы заставляет прийти к выводу о недопущении самолечения, что может привести к плачевному результату.
Вопрос-ответ
Каковы причины инфекции мочевыводящих путей у мужчин?
Причиной возникновения инфекции мочевыводящих путей являются такие возбудители, как кишечная палочка. В норме она находится в микрофлоре толстого кишечника, но при нарушениях гигиены является возбудителем острого пиелонефрита или иных осложнений в системе почек.
Как понять, что проблемы с мочеполовой системой у мужчин?
Проблемы с мочеполовой системой у мужчин могут проявляться через различные симптомы, такие как боль или жжение при мочеиспускании, частые позывы к мочеиспусканию, затруднения с началом или завершением мочеиспускания, изменения в цвете или запахе мочи, а также наличие крови в моче или семенной жидкости. Также стоит обратить внимание на боли в области таза или нижней части живота, а также на снижение либидо или эректильные дисфункции. Если вы заметили один или несколько из этих симптомов, рекомендуется обратиться к врачу для диагностики и лечения.
Каковы причины бактерий в моче у мужчин?
Основной причиной попадания и распространения бактерий в моче служат случайные половые связи, незащищенный секс. У мужчин частым фактором риска развития бактериурии служит бактериальный простатит, реже — баланопостит, орхит, эпидидимит.
Советы
СОВЕТ №1
Регулярно проходите медицинские обследования. Это поможет выявить инфекции на ранних стадиях, когда лечение будет наиболее эффективным. Не забывайте сообщать врачу о любых симптомах, таких как боль при мочеиспускании или частые позывы в туалет.
СОВЕТ №2
Соблюдайте правила личной гигиены. Регулярное мытье половых органов и использование чистого нижнего белья могут значительно снизить риск развития инфекций. Также старайтесь избегать использования чужих полотенец и предметов личной гигиены.
СОВЕТ №3
Обратите внимание на свой образ жизни. Употребление достаточного количества воды, сбалансированное питание и регулярные физические нагрузки помогут укрепить иммунную систему и снизить вероятность инфекций мочеполовой системы.
СОВЕТ №4
Избегайте незащищенных половых контактов. Использование презервативов не только защитит вас от инфекций, передающихся половым путем, но и поможет предотвратить развитие мочеполовых инфекций. Если у вас есть постоянный партнер, обсудите с ним необходимость регулярного тестирования на инфекции.
